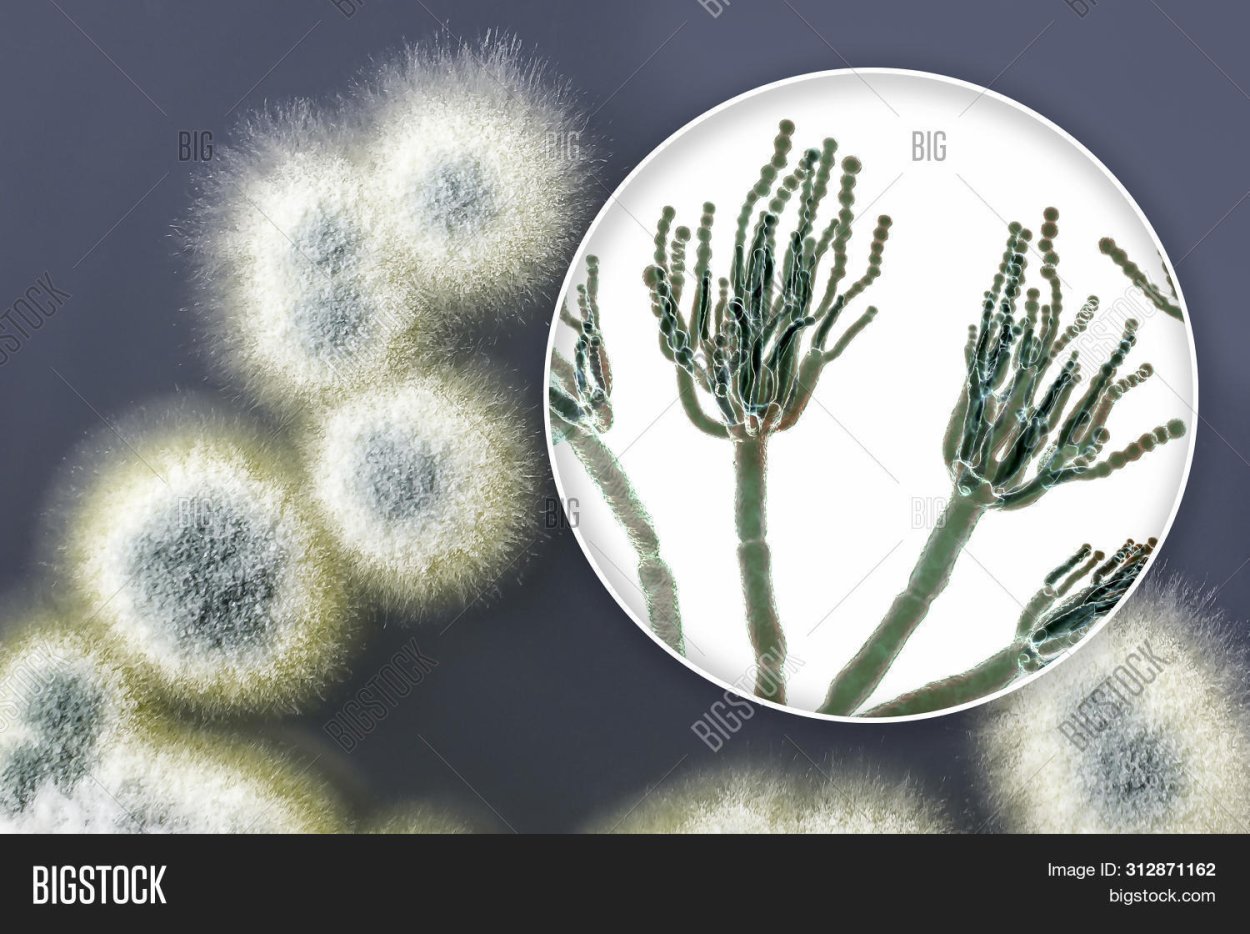
Penicillium janczewskii
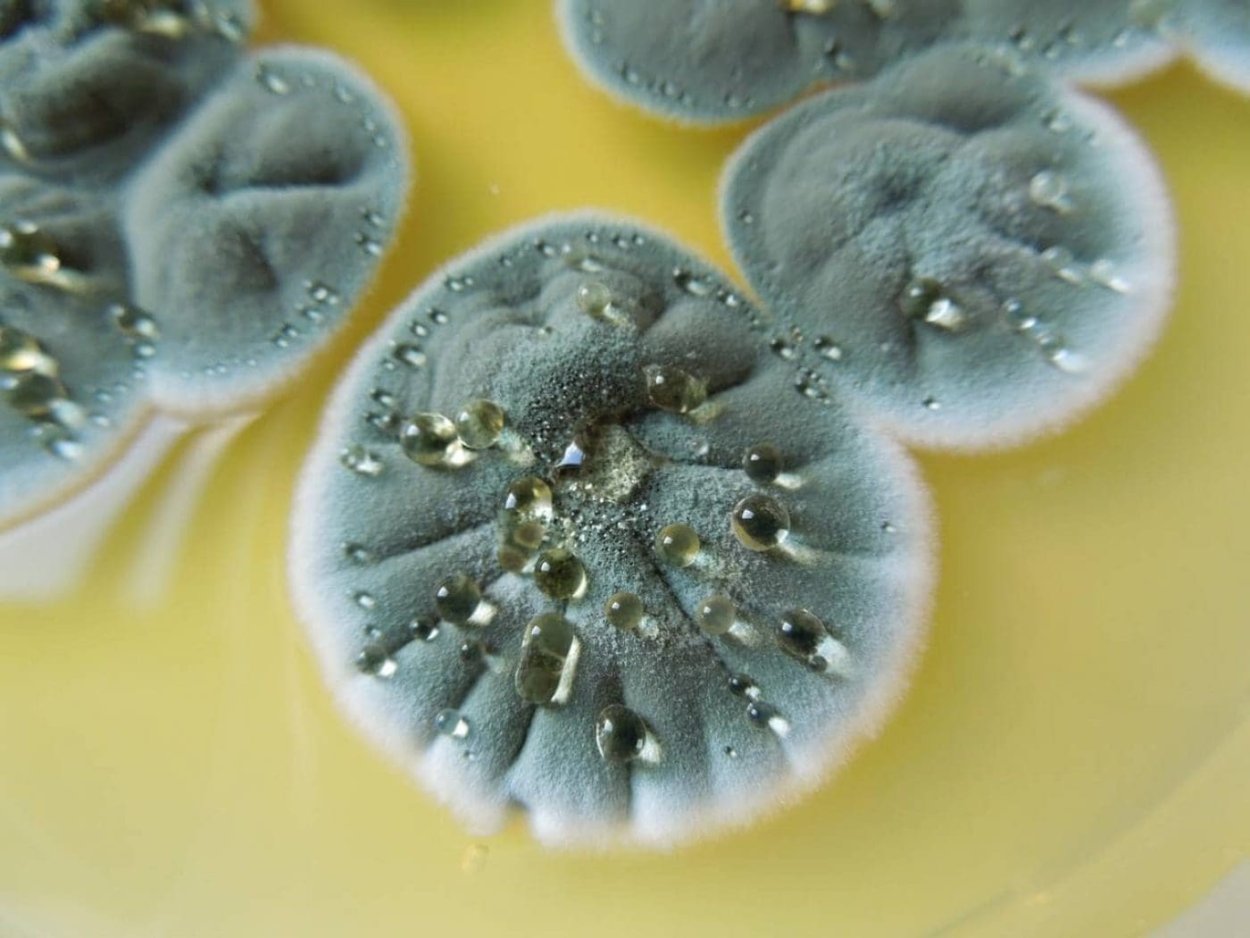
Penicillium citrinum
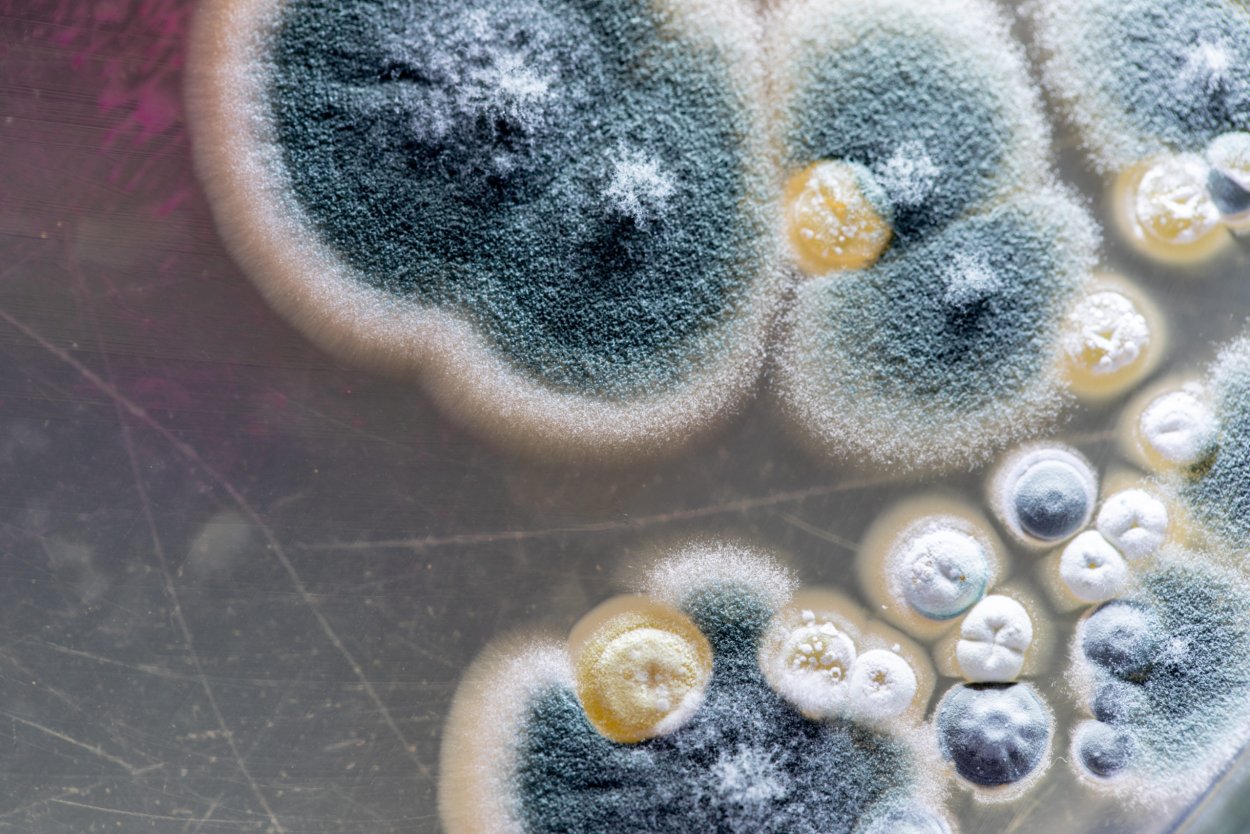
Мукоромикоз черная плесень
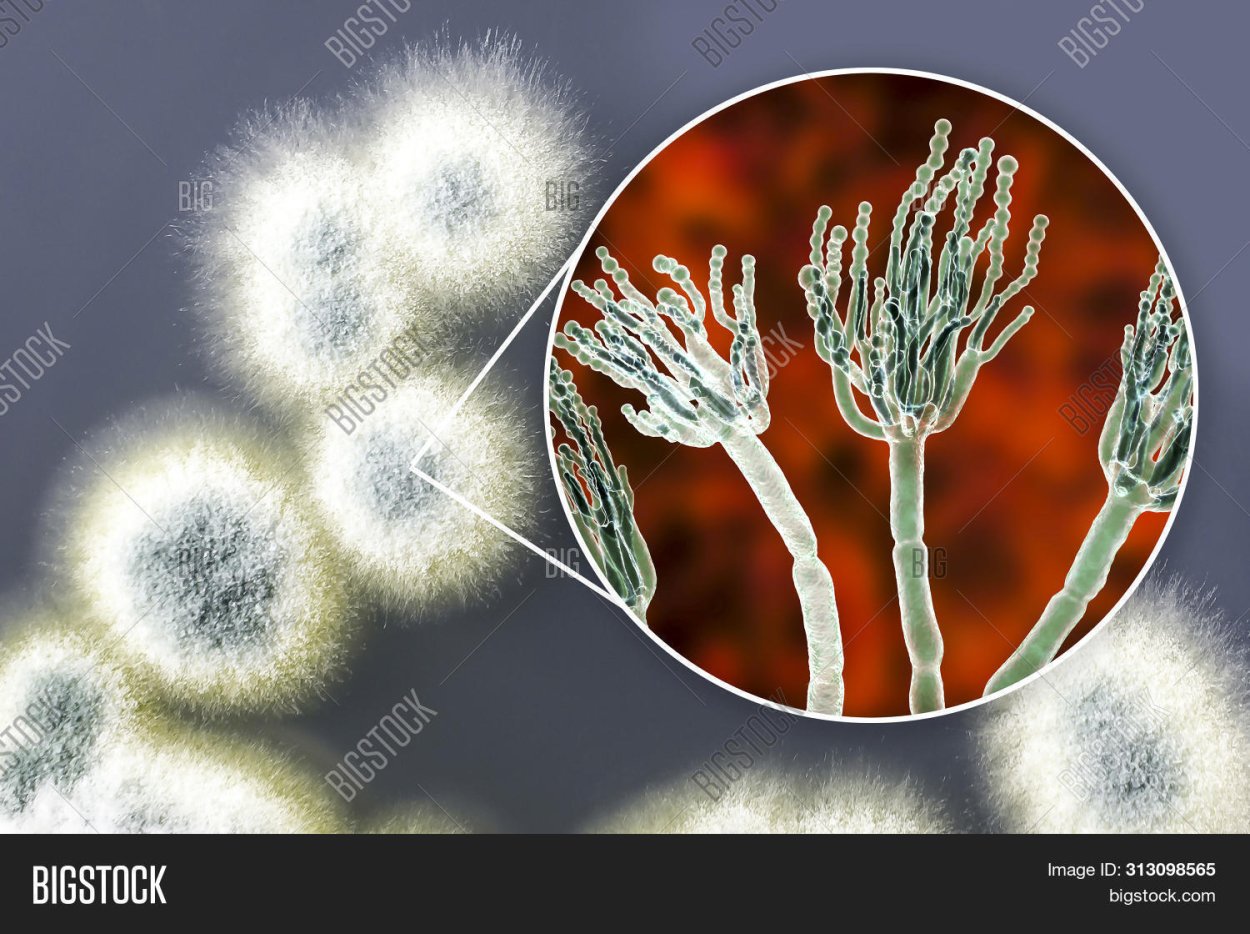
Пенициллиум Рубенс

Виды плесневых грибов

Грибы плесневые дрожжи Шляпочные

Плесневые грибы спорангии

Плесневые грибы на хлебе под микроскопом

Грибы плесень

Плесень Мухор микроскопом

Гриб пеницилл на хлебе

Группы грибов Шляпочные и плесневые

Aspergillus flavus Toxins

Гриб мукор и пеницилл

Плесневые грибы аспергилл чёрный

Микотоксикозы микроскопические грибы

Грибы рода Thamnidium

Серая плесень под микроскопом

Плесневые грибы

Пеницилл симбиоз

Микотоксины плесневых грибов

Плесневые грибы

Плесневые грибки

Пенициллин и мукор

Цвет плесени

Правда или миф

Плесневые грибы ризопус

Строение гриба мицелий
Penicillium janczewskii

Плесневые грибы Rhizopus

Пеницилл золотистый

Грибница плесени

Aspergillus flavipes

Колонии пеницилла

Гриб пеницилл плесень на хлебе

Плесневые грибочки

Плесневые грибы ризопус

Порча продуктов плесенью

Грибок кандида плесневые грибы
Penicillium citrinum

Спорангий аспергилла

Белая плесень мукор

Aspergillus flavus Токсин

Микроскопические грибы fungi

Плесневые грибы на хлебе
Мукоромикоз черная плесень

Плесень для человека вредная

Гифальные (плесневые) грибы

Миксомицеты царство

Мицелий Aspergillus под микроскопом

Грибы плесневые, Шапочные, дрожжи

Плесневые грибы

Необычная плесень

Сапрофиты слизевики

Гриб пеницилл на хлебе

Триходерма Петри

Плесень Penicillium roqueforti

Одноклеточные грибы пеницилл

Pilobolus crystallinus

Плесневые грибы ризопус

Споры плесневых грибов

Строение зеленой плесени

Грибы мукор на чашке Петри

Гриб пеницилл
Пенициллиум Рубенс

Аспергилл грибок плесень

Плесневелые грибки

Плесневые грибы Mucor

Гриб мукор и пеницилл строение

Гриб мукор

Плесневые грибы представители

Грибы